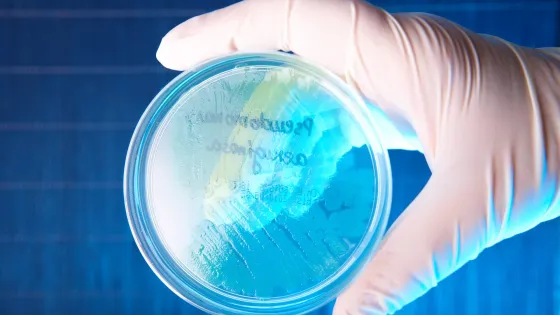
8437007

- Китайские молекулярные биологи модифицировали геном синегнойной палочки для выработки свечения при формировании колоний на поверхности микропластика.
- Созданный биосенсор позволяет быстро и надежно оценивать концентрации микропластика в различных природных средах.
- Биосенсор позволяет выявлять микропластик в пробах различных материалов из окружающей среды и вести масштабные наблюдения за его распространением.
- Модификации в структуре ДНК синегнойной палочки заставляют ее вырабатывать зеленое флуоресцентное излучение после прикрепления к поверхности микрочастицы.
- Микробы успешно колонизируют и «подсвечивают» даже небольшие количества микрочастиц из полистирола и полиэтилентерфталата.
- Сила свечения бактерий растет по мере увеличения числа пластиковых частиц, позволяя точно определять их концентрацию.
- Микробы остаются жизнеспособными на протяжении нескольких дней при хранении в холодильнике, что позволяет использовать их для полевых исследований в удаленных регионах.
Cинегнойную палочку превратили в светящийся детектор частиц микропластика
3 сен 2025
Краткий пересказ
от нейросети YandexGPT
Обложка: Изображение из статьи. © Monika Wisniewska/Shutterstock/FOTODOM